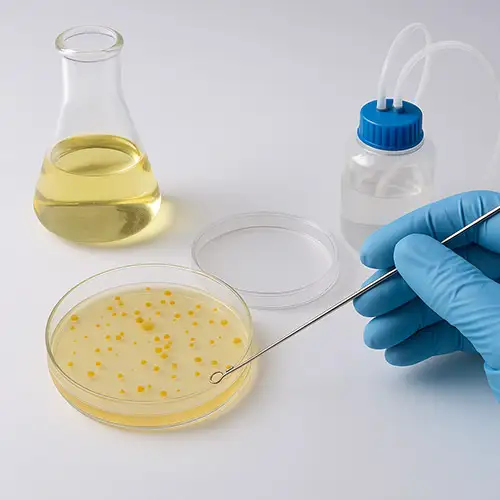
کشت میکروارگانیسم ها
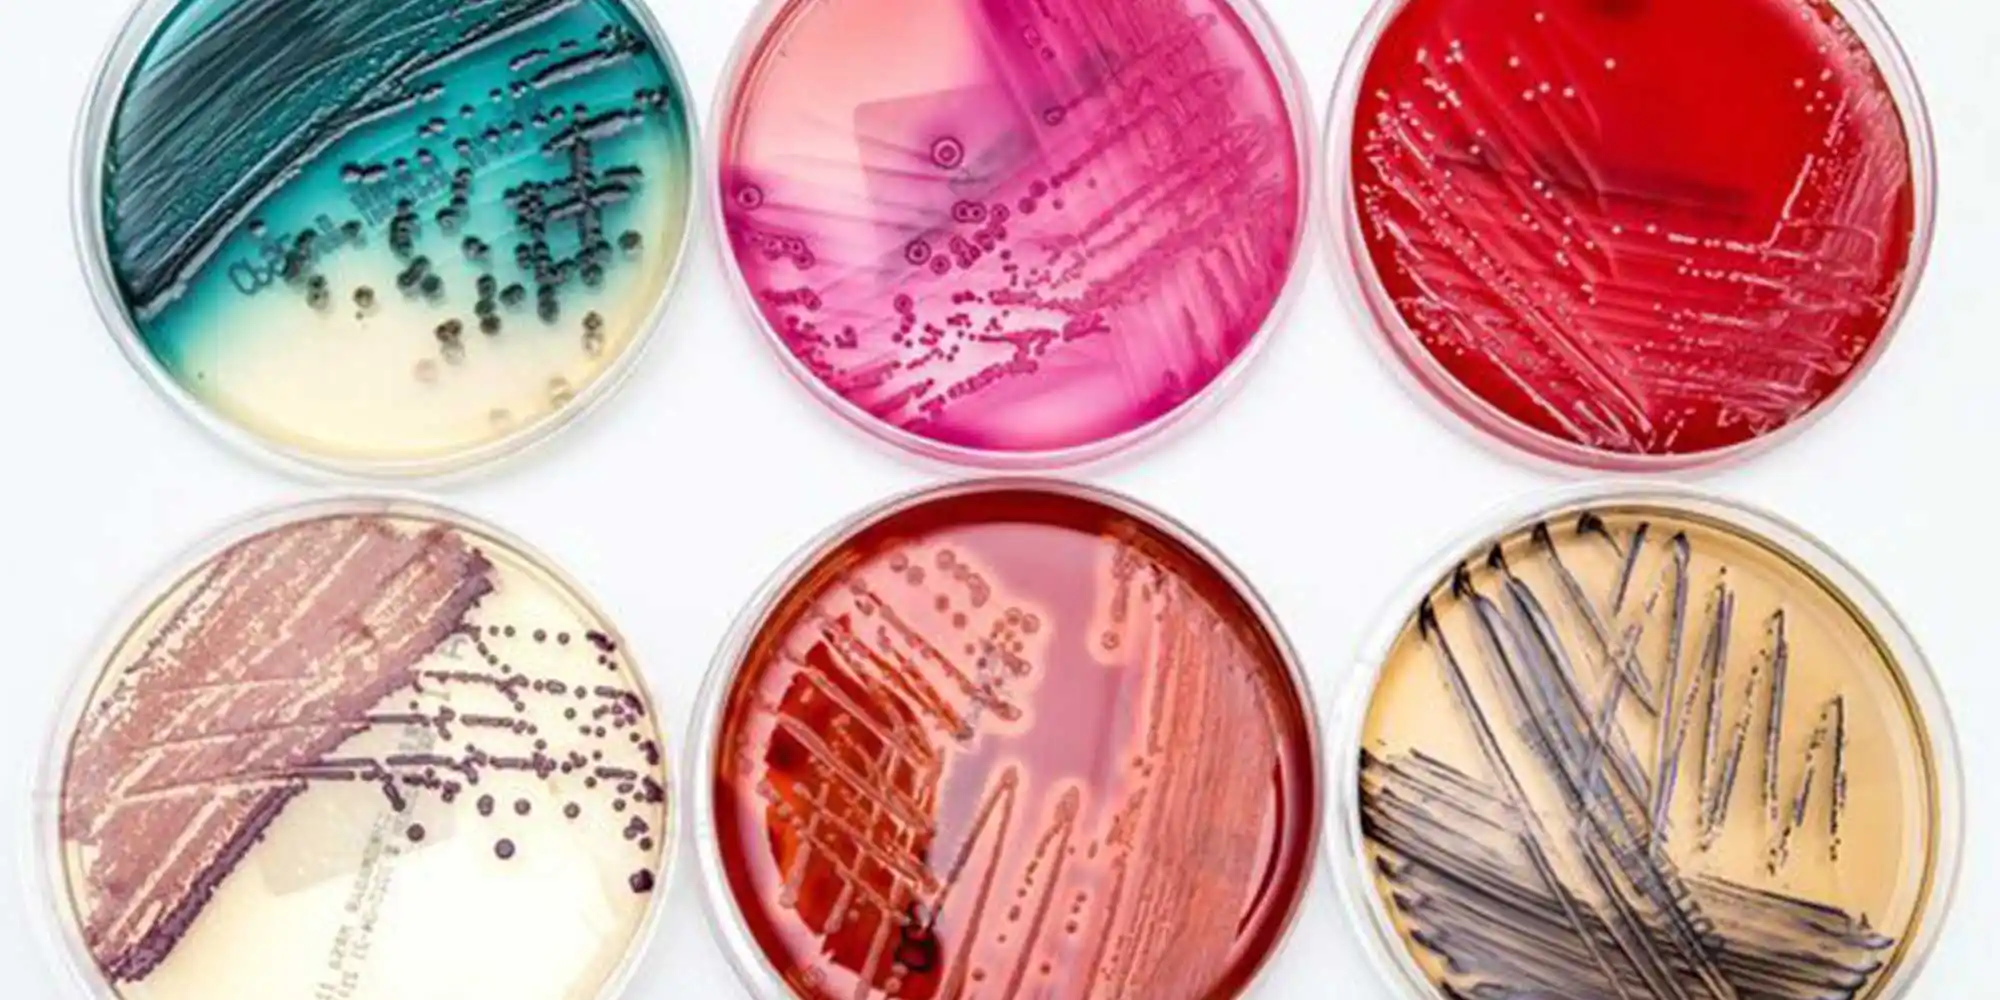
کشت میکروبی

کشت میکروبی چیست و چه روش ها و کاربردهای در بیوتکنولوژی دارد؟
کشت میکروبی به معنای رشد و تکثیر میکروارگانیسم ها مانند باکتری ها، مخمرها و قارچ های تک سلولی در محیط های کنترل شده است. این فرآیند در آزمایشگاه ها و صنایع زیستی برای مقاصد تحقیقاتی، تشخیصی و تولیدی به کار می رود. کشت میکروارگانیسم ها به دانشمندان امکان می دهد تا خصوصیات میکروارگانیسمها را مطالعه کرده و محصولات با ارزش زیستی مانند آنتی بیوتیک ها، آنزیم ها و پروتئین های نوترکیب را تولید نمایند.
انواع محیط های کشت
- محیط های جامد: معمولاً حاوی آگار هستند و برای جداسازی کلونی ها و شناسایی گونه ها استفاده می شوند. (مثال: محیط Nutrient Agar).
- محیط های مایع: بدون آگار بوده و برای رشد انبوه میکروارگانیسمها در مقیاس زیاد استفاده می شوند. (مثال: محیط Nutrient Broth).
- محیط های انتخابی: حاوی مواد شیمیایی یا آنتی بیوتیک ها هستند که رشد برخی گونه ها را مهار کرده و تنها گونه های هدف را رشد می دهند. (مثال: MacConkey Agar برای باکتری های گرم منفی).
- محیط های افتراقی: به کمک شاخص های شیمیایی، گونه های مختلف را از هم تفکیک میکنند. (مثال: Blood Agar برای تشخیص نوع همولیز).
تکنیک های رایج در کشت میکروبی
- استریک پلیت (Streak Plate): برای جداسازی کلونی های خالص روی سطح آگار.
- پور پلیت (Pour Plate): افزودن رقت های میکروبی به محیط مذاب آگار برای شمارش کلونی ها.
- اسپرد پلیت (Spread Plate): پخش کردن سوسپانسیون میکروبی روی سطح آگار با استفاده از میله شیشه ای استریل.
- سابکالچر (Subculture): انتقال کلونی یا کشت قدیمی به محیط تازه برای حفظ و تکثیر میکروارگانیسم.
اصول استریل و کنترل آلودگی
کشت میکروبی همانند کشت بافت گیاهی نیازمند رعایت دقیق شرایط استریل است. استفاده از هود لامینار، ضدعفونی سطوح با اتانول ۷۰٪، استریل کردن وسایل با اتوکلاو و رعایت تکنیک های آسپتیک برای جلوگیری از آلودگی الزامی است.
روشهای نگهداری میکروارگانیسم ها
کوتاه مدت
برای نگهداری میکروارگانیسمها روش های مختلفی وجود دارد که بسته به مدت زمان مورد نظر و حساسیت گونه انتخاب می شوند. در شرایط کوتاه مدت، اغلب از محیط های جامد یا مایع در دمای چهار درجه سانتی گراد استفاده می شود. در این حالت میکروارگانیسمها می توانند برای چند روز تا چند هفته بدون کاهش قابل توجه در توانایی رشد خود باقی بمانند. این روش بیشتر برای آزمایش های متوالی و کارهای روزمره آزمایشگاهی مناسب است.
بلند مدت
در مقابل، برای نگهداری بلندمدت نیاز به تکنیک های پیشرفته تری وجود دارد. یکی از رایج ترین روش ها استفاده از انجماد در دماهای بسیار پایین، مانند منفی هشتاد درجه سانتی گراد است. در این حالت، اغلب از گلیسرول به عنوان ماده محافظ استفاده می شود تا از آسیب غشای سلولی در اثر تشکیل کریستال های یخ جلوگیری شود.
روش دیگر لیوفیلیزاسیون یا همان خشک کردن انجمادی است که در آن میکروارگانیسم ها ابتدا منجمد و سپس با کاهش فشار، آب آن ها به صورت مستقیم از یخ به بخار خارج می شود. این فرآیند باعث میشود سلول ها برای سال ها بدون نیاز به شرایط سرمایشی خاص زنده بمانند.
کاربردهای کشت میکروبی
کشت میکروبی در حوزه های گوناگون علمی و صنعتی نقش حیاتی دارد. در پژوهش های بنیادی، این روش ابزاری کلیدی برای مطالعه ژنتیک، فیزیولوژی و متابولیسم میکروارگانیسم ها است. در صنایع دارویی، کشت میکروبی برای تولید آنتی بیوتیک ها، واکسن ها و پروتئین های نوترکیب به کار گرفته می شود و بخش عمده ای از داروهای مدرن بر پایه همین فرآیندها تولید میشوند.
کاربرد کشت میکروبی در کشاورزی
صنعت کشاورزی نیز از این حوزه بی بهره نمانده و کشت میکروبی به تولید کودهای زیستی، بهبود جذب عناصر غذایی و کنترل بیولوژیک آفات کمک میکند. همچنین در حوزه محیط زیست، توانایی میکروارگانیسم ها در تجزیه آلاینده ها و تصفیه فاضلاب به عنوان راهکاری پایدار مورد استفاده قرار می گیرد. در صنایع غذایی نیز نقش میکروارگانیسم ها غیرقابل انکار است؛ از تولید ماست و پنیر گرفته تا نان و نوشیدنی های تخمیری، همه به کمک کشت های میکروبی امکان پذیر میشوند.
چالش ها
با وجود مزایا، کشت میکروبی با چالش های جدی همراه است. یکی از مهمترین مشکلات، آلودگی نا خواسته توسط میکروارگانیسم های دیگر است. این آلودگی می تواند نتایج آزمایش را تغییر داده یا کل فرآیند تولید صنعتی را مختل کند. همچنین تجهیزاتی مانند بیورآکتورها و سیستم های پیشرفته استریل سازی هزینه بر هستند و برای بسیاری از مراکز کوچک دسترس پذیر نیستند. علاوه بر این، شرایط کنترل شده آزمایشگاهی همیشه بازتاب دقیقی از محیط طبیعی نیست و این تفاوت می تواند باعث تغییر رفتار میکروارگانیسم ها شود.
چشم انداز آینده کشت میکروارگانیسم ها
کشت میکروبی در حال ورود به مرحله ای نوین است که در آن فناوری های پیشرفته نقش محوری ایفا می کنند. بیورآکتورهای مدرن امکان کنترل دقیق تر دما، pH و اکسیژن را فراهم کرده اند و بازده تولید مواد زیستی را به طور چشمگیری افزایش می دهند. مهندسی ژنتیک و زیست فناوری نوین نیز با اصلاح مسیرهای متابولیکی میکروب ها، توانسته اند تولید سوخت های زیستی، داروهای نوترکیب و مواد زیست پایه را اقتصادی تر و پایدارتر کنند. علاوه بر این، فناوری نانو و هوش مصنوعی در حال تغییر روش های سنتی کشت میکروبی هستند و آینده ای را نوید می دهند که در آن می توان فرآیندها را با دقتی بی سابقه طراحی و کنترل کرد.
جمع بندی
کشت میکروبی یکی از پایه های اصلی زیست فناوری، پزشکی و صنایع غذایی است. آشنایی با تکنیک های کشت و نگهداری، شناخت کاربردهای گسترده و توجه به چالش ها، مسیر استفاده بهینه از ظرفیت های عظیم میکروارگانیسم ها را هموار می کند. با پیشرفت فناوری، این حوزه در آینده نزدیک نقشی حتی مهم تر در حل مسائل جهانی همچون امنیت غذایی، بهداشت و انرژی ایفا خواهد کرد.

خیلی ممنون از مطالب خوبتون
خوشحالیم مورد توجه شما قرار گرفته